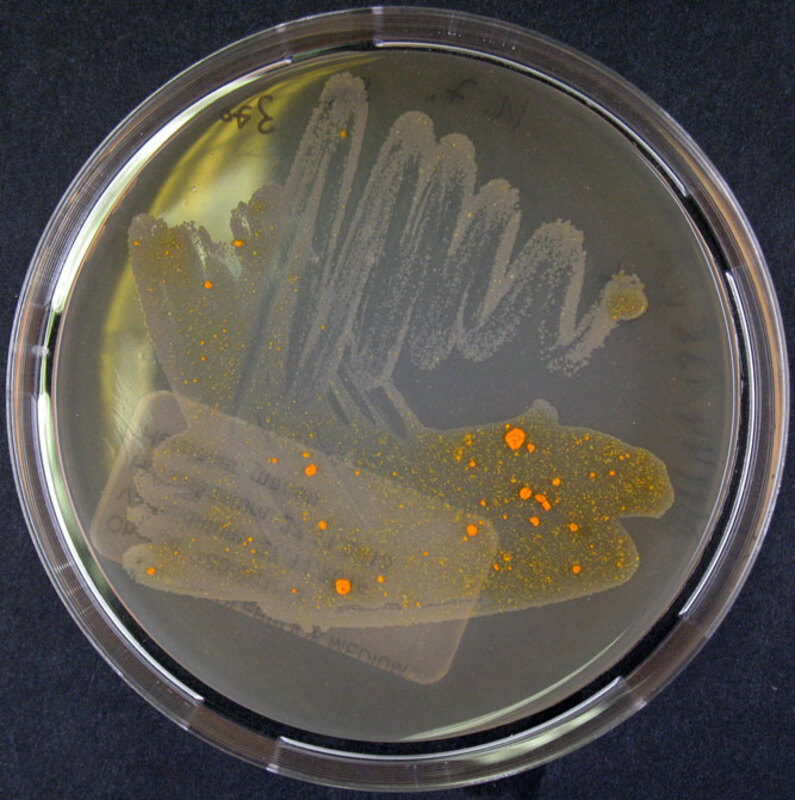
Амикацин безопасен и улучшает респираторные симптомы при легочных заболеваниях, вызванных M. avium complex

Амикацин в течение 6 месяцев улучшал респираторные симптомы у взрослых с недавно диагностированным или рецидивирующим заболеванием легких, вызванным микобактериями комплекса Mycobacterium avium (MAC), говорится в докладе на Международной конференции Американского торакального общества.
Ранее уже сообщалось о результатах исследования ARISE фазы 3, изучавшего эффективность липосомной суспензии для ингаляций амикацина (ALIS) для лечения легочных заболеваний, вызванных микобактериями, среди вновь диагностированных пациентов. В новом рандомизированном двойном слепом мультирегиональном исследовании 99 взрослых с недавно диагностированным или рецидивирующим заболеванием легких MAC, которые еще не начали принимать антибиотики, оценивали качество жизни при бронхоэктазах по опроснику QOL-B, методики для оценки результатов по отзывам пациентов, а также определяли, как различаются респираторные симптомы и микробиологические показатели между теми, кто получает ALIS один раз в день, и теми, кто получает плацебо один раз в день в течение 6 месяцев.
«В настоящее время не существует валидированного метода для пациентов с MAC-заболеваниями легких», - сообщил Чарльз Л. Дейли, заведующий отделением микобактериальных и респираторных инфекций и профессор кафедры медицины в National Jewish Health во время своего выступления. «Опросник QOL-B был валидирован у пациентов с бронхоэктазами без МАС, но не у пациентов с MAC», - добавил он. Что касается микробиологических показателей, то исследователи ежемесячно культивировали два образца мокроты в агаре и бульоне от каждого пациента и наблюдали рост культуры или «отсутствие роста MAC на агаровой и бульонной средах во всех культурах мокроты», - сказал Дейли.
Из общей когорты 48 пациентов (средний возраст 71,5 года, 66,7% женщин, 85,4% белых, 72,9% с первым диагнозом MAC) получали ALIS плюс фоновую схему на основе макролидов, а 51 пациент (средний возраст 67 лет, 88,2% женщин, 76,5% белых, 72,5% с первым диагнозом MAC) получал плацебо плюс фоновую схему на основе макролидов. Большая доля пациентов, получавших ALIS, по сравнению с плацебо, достигла улучшения (43,8 % против 33,3 %). При оценке роста культур на 6-м и 7-м месяцах исследователи отметили более высокие показатели в группе ALIS по сравнению с группой плацебо во время обеих оценок (6-й месяц - 80,6% против 63,9%; 7-й месяц - 78,8% против 47,1%). Дейли также подчеркнул, что у пациентов, получавших ALIS, медиана времени до первого выделения культуры была более быстрой по сравнению с пациентами, получавшими плацебо (1 месяц против 2 месяцев).
Среди тех, кто соответствовал критериям исследования для выделения культуры, у меньшего числа пациентов в группе ALIS по сравнению с группой плацебо наблюдался рецидив MAC (12,8% против 50%). Дэйли добавил: «К счастью, ни у одного пациента из обеих групп в ходе исследования не развилась резистентность к макролидам или амикацину». Что касается безопасности, то пациенты, получавшие ALIS, не сообщили о каких-либо новых или неожиданных побочных эффектах. У большинства пациентов в каждой группе наблюдались побочные эффекты, связанные с лечением (ALIS - 91,7%; плацебо - 80,4%). У пациентов, получавших ALIS, чаще всего возникала дисфония (41,7%), затем следовали кашель (27,1%), диарея (27,1%) и COVID-19 (12,5%). В группе ALIS произошло семь серьезных побочных явлений, что сопоставимо с восемью серьезными побочными явлениями, наблюдавшимися в группе плацебо. Касательно побочных эффектов, относящихся к категории ототоксичности, таких как головокружение, шум в ушах и вертиго, то, по словам Дэйли, в обеих группах наблюдались низкие показатели, и они не сильно отличались друг от друга.
«Следующее, чего мы ждем, - это 15-месячное подтверждающее исследование, которое проводится в настоящее время», - сказал Дейли. «В нем оценивается эффективность и безопасность ALIS в той же популяции пациентов. Разница в том, что это 12-месячное лечение, а затем оценка через 3 месяца после окончания терапии, то есть вдвое длиннее, чем ARISE».